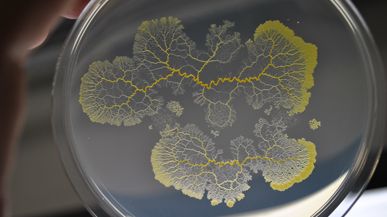

Welcome to the Institute for Biophysics
Institute for Biophysics

Welcome to the Institute for Biophysics

© Brüggemann
© Universität Bremen/Biophysik
Döbereiner
Hans-Günther Döbereiner is interested in the Biological Physics of Cellular Systems and Soft Matter.
more


